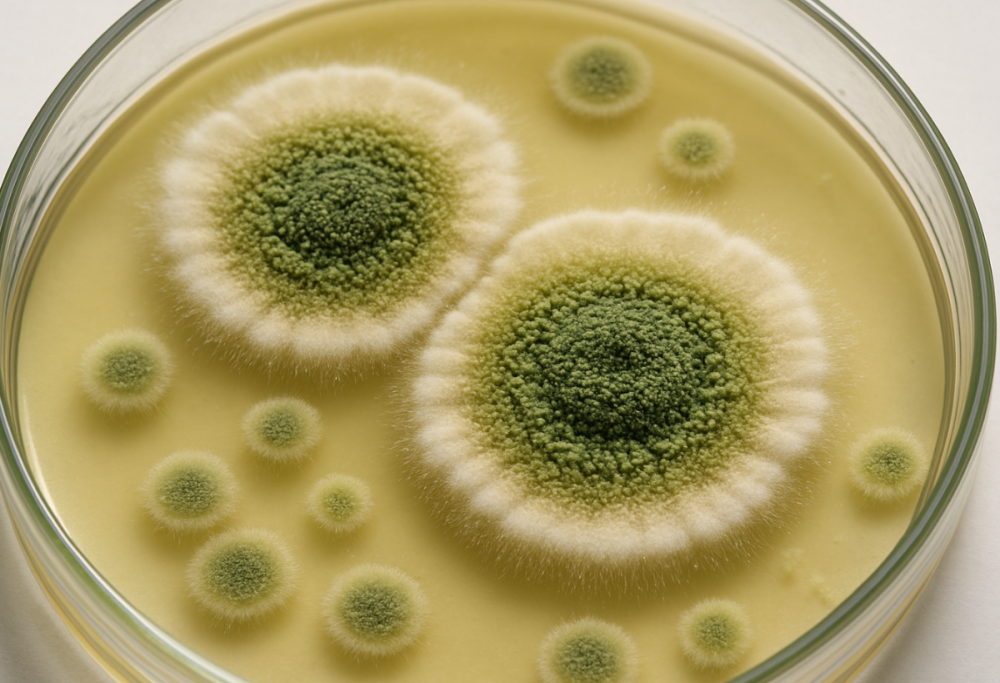

Dal mistero di Tutankhamon a cura: la scoperta sorprendente
L’Aspergillus flavus, legato al mistero di Tutankhamon, oggi sorprende gli scienziati con un potenziale medico inaspettato
10 Luglio 2025
Per anni il suo nome è stato avvolto da paura e mistero a causa della misteriosa maledizione di Tutankhamon. Le sue spore invisibili, un tempo ritenute portatrici di sventura dalle umide pareti di antiche tombe, stanno oggi rivelando un potenziale inaspettato.
Quel temuto fungo patogeno, l’Aspergillus flavus, si sta trasformando in un insospettabile alleato nella lotta contro una delle sfide più grandi dell’umanità: il cancro.
Lo studio
Un recente studio pubblicato su Nature Chemical Biology ha rivelato che l’aspergillus flavus produce molecole con una straordinaria capacità di attaccare le cellule tumorali, in particolare quelle leucemiche, aprendo così nuove strade per innovative cure oncologiche.
Per giungere a questo risultato gli scienziati sono partiti dalla consapevolezza che i funghi sono capaci di generare una vasta gamma di sostanze bioattive (la penicillina ne è un esempio lampante), per poi concentrarsi sui RiPPs, peptidi sintetizzati ribosomialmente e modificati post-traduzionalmente.
Nel caso specifico dell’Aspergillus flavus, i ricercatori hanno identificato e isolato quattro nuove molecole, battezzate asperigimicine, di cui due hanno mostrato, in laboratorio, una notevole efficacia nel combattere le cellule della leucemia. Addirittura, con l’aggiunta di un lipide che ne potenzia l’azione e ne favorisce l’assorbimento, una di queste è riuscita a eguagliare l’efficacia di alcune terapie di prima linea già in uso.
Il meccanismo d’azione
L’aspetto più affascinante di questa scoperta risiede nel meccanismo d’azione: queste molecole sono capaci di interferire direttamente con la replicazione delle cellule tumorali, bloccandone la proliferazione. Sebbene non si possa ancora parlare di una cura definitiva, il prossimo passo sono i test su modelli animali, dopo cui sarà possibile procedere con eventuali studi clinici sull’uomo, con l’obiettivo di sviluppare nuovi farmaci mirati specificamente contro la leucemia e, potenzialmente, anche contro altri tipi di tumore. Se i test in vivo confermeranno l’efficacia già osservata in vitro, le asperigimicine potrebbero davvero segnare l’inizio di una nuova generazione di terapie oncologiche.


















